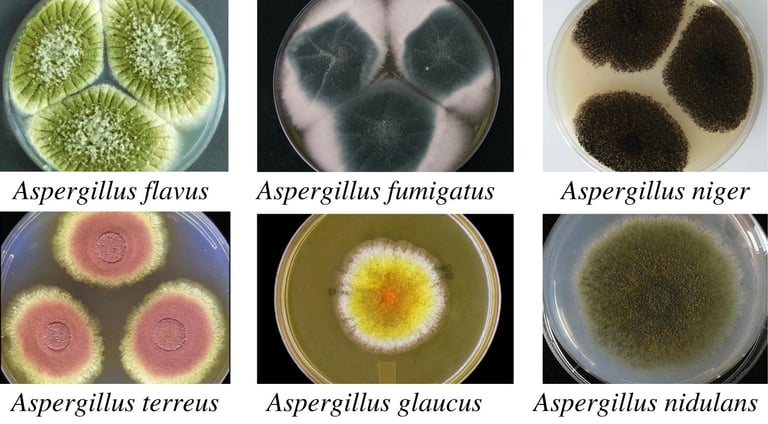

Types of Mold in Homes | Indoor Mold Identification Guide – The Woodlands TX
Learn the most common types of mold in homes, what they mean for your home, and when to call a licensed mold assessment consultant in The Woodlands, TX. Types of indoor mold, black mold, Aspergillus, Penicillium mold, Cladosporium, Stachybotrys Chartarum, mold inspection The Woodlands TX
4/21/20263 min read
Mold is a natural part of the environment, but when it begins growing indoors, it can quickly become a serious concern. Different types of mold vary in appearance, growth patterns, and potential health impact.
As a licensed Mold Assessment Consultant, one of the most common questions we hear is:
👉 “What kind of mold is this — and should I be worried?”
The truth is, you cannot reliably identify mold by appearance alone. Proper testing and analysis are required. However, understanding the most common indoor mold types can help you recognize potential issues early.
🟢 1. Aspergillus
Common Locations:
HVAC systems
Walls and insulation
Dust and air ducts
Appearance:
Powdery or fuzzy
Colors range from green, yellow, white, to brown
Why It Matters:
Aspergillus is one of the most common indoor molds. Some species can produce allergens and irritants, while others may produce toxins under certain conditions.
🔵 2. Penicillium
Common Locations:
Water-damaged materials
Carpet, padding, and insulation
Wallpaper and fabrics
Appearance:
Blue or green
Velvety or fuzzy texture
Why It Matters:
Penicillium spreads quickly and is often associated with water damage. It can contribute to poor indoor air quality if not properly addressed.
⚫ 3. Stachybotrys (The Infamous Black Mold)
Common Locations:
Drywall and sheetrock
Ceiling tiles
Areas with prolonged moisture exposure
Appearance:
Dark green to black
Slimy or wet-looking
Why It Matters:
Often referred to as “black mold,” this type typically develops after long-term moisture problems. It is less common than many believe but indicates a significant underlying issue that must be corrected.
🟤 4. Cladosporium
Common Locations:
Window sills
Bathrooms
HVAC systems
Appearance:
Dark green, brown, or black
Spotty or patchy
Why It Matters:
Cladosporium is frequently found both indoors and outdoors. It thrives in damp areas and can spread through air circulation systems.
🟡 5. Alternaria
Common Locations:
Bathrooms and showers
Under sinks
Around leaks
Appearance:
Dark green or brown
Velvety texture
Why It Matters:
Alternaria is commonly associated with moisture-prone areas and can spread rapidly when humidity levels are high.
⚠️ Important: Visual Identification Isn’t Enough
Many molds look similar, and multiple types often grow together.
👉 A dark spot on drywall could be:
Cladosporium
Stachybotrys
Or something entirely different
That’s why professional testing is critical.
At Mold Consultant Group, we use:
Air sampling (spore traps)
Surface sampling (tape lifts, swabs, wall checks)
Moisture mapping & infrared imaging to accurately determine what’s present and whether action is needed.
🏠 What Causes Indoor Mold Growth?
Mold growth always comes down to one thing:
👉 Moisture
Common sources include:
Water leaks (roof, plumbing, HVAC)
Flooding or storm damage
High indoor humidity
Poor ventilation
🚨 When Should You Call a Professional?
You should consider a professional mold assessment if:
You see visible mold growth
You notice a musty odor
You’ve had recent water damage
You’re experiencing unexplained indoor air quality concerns
You’re buying or selling a home
Serving The Woodlands & Surrounding Areas
We provide unbiased mold testing and inspections throughout:
& surrounding Northwest Houston areas
Schedule a Mold Inspection
If you’re concerned about mold in your home or property, don’t guess — get clear answers.
Mold Consultant Group
📞 832-280-4747
🌐 www.moldconsultantgrp.com
Final Thoughts
Not all mold is the same — but all indoor mold growth should be taken seriously. The key is identifying:
✔ What type is present
✔ Why it’s growing
✔ Whether remediation is necessary
A proper assessment gives you the clarity needed to move forward with confidence.

Mold Consultant Group, LLC
Contact:
info@moldconsultantgrp.com
832-280-4747
© 2026. Mold Consultant Group All rights reserved.
Mold Inspections
Water Damage Inspections
Air Quality Testing
Mold Testing and Identification
Mold Assessments
Mold Protocols
Comparative remediation and repair estimates




Mold Consultant Group
PO Box 206, Montgomery TX 77356
Service Area: The Woodlands, Spring, Conroe, TX & surrounding areas
Mold Consultant Group is a mobile, service-area business. We provide on-site inspections by appointment only and do not operate a public walk-in office.
HOURS:
Monday thru Thursday 9 AM - 5 PM
Friday 9 AM - 4 PM
Saturday - By Appointment
Services
Get a Free Mold Assessment Recommendation


